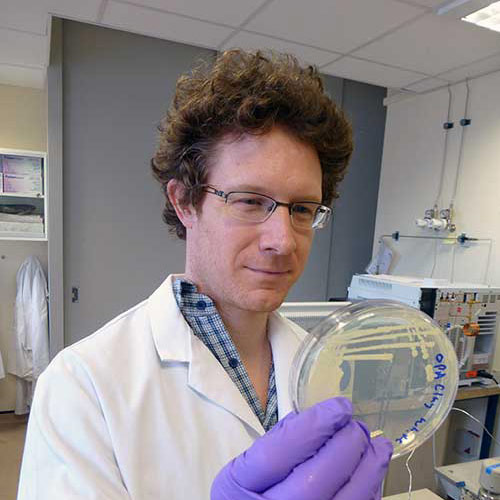

Simon currently leads the microbiology research at BGS. His team works on understanding the interactions between microorganisms living beneath the Earth’s surface and their environment. This includes understanding how our use of the subsurface for waste disposal, heat extraction and energy storage affects the microbial communities that are there and how that could affect industrial operations through microbiologically influenced corrosion, bioclogging and the microbial production and consumption of gases. Our laboratory also works on methane cycling in soils, groundwater and wetlands, biomining and the stabilisation of slopes and coastal environments though microbial precipitation of minerals.
Simon Gregory’s biography
- 2012 – Geomicrobiology laboratory manager and research lead
- 2011 – 2012: Research Assistant, Institute of Life Science, Swansea University
- 2009 – 2010: Technician, Centre for Sustanable Aquatic Research, Swansea University
- 2008 – 2008: Research Assistant, School of Biological Sciences, Swansea University
- 2004 – 2008: PhD Microbial ecology of constructed wetlands. Swansea University
- 2002 – 2004: Technician, Department of Medical and Community Genetics, Imperial College London
- 1998 – 1999: MSc Neuroscience, King’s College London
- 1994 – 1997: BSc Geology, University of Birmingham
- 1994 – 1997: BSc(hons) Natural Sciences, Durham University
Research interests
- Subsurface microbiology in relation to carbon capture and storage and radioactive waste disposal: Understanding the potential impact of microbial activity on radioactive waste disposal, carbon capture and storage, hydrogen storage and shallow geothermal energy.
IDRIC project
Microbiology Society: An interview with Simon Gregory - Biomining and bioleaching of rare earth elements: Exploring the usefulness of social media mining in the applied natural geohazard sciences.
Met4Tech project
SERUM project (pdf) - Cycling in soils, groundwater and wetlands: Understanding the role of microorganisms in producing and consuming methane in soils, groundwater and wetlands
ORCID: 0000-0002-3410-1390
Current projects and collaboration
- 2017 – 2020: ERA-Net Cofund ACT project ELEGANCY – Enabling a low-carbon economy via hydrogen and CCS. Elegancy website
- 2017 – 2021: Supervising PhD studentship in the BBSRC/NERC STARS (Soil Training and research Studentships) CDT: Turning down the gas: what is the potential for microbial mitigation of methane leakage from soils? STARS CDT web site
- 2015 – 2019: Horizon 2020 MIND (Microbes In Nuclear Disposal) (EU project 661880). Investigating the role of microbes in corrosion and alteration of repository materials MIND website
- 2015 – 2019: NERC Security of Mineral Resources grant: SoS RARE (Security of supply of rare earth elements). Understanding the role of microbes in mobilisation of rare earth elements and application to bioprocessing. SoS RARE website
- 2014 – 2018: Supervising EngD studentship in the EPSRC Centre for Doctoral Training in Carbon Capture and Storage and Cleaner Fossil Energy: Mitigating the impact of microbes on the storage of carbon dioxide EPSRC EngD project website
Key papers
Bott, T, Shaw, G, and Gregory, S. 2023. A simple method for testing and controlling inhibition in soil and sediment samples for qPCR. Journal of Microbiological Methods, Vol. 212 106795
Barnett, M J, Farr, G J, Shen, J, and Gregory, S P. 2023. Groundwater microbiology of an urban open‐loop ground source heat pump with high methane. Groundwater. Vol. 61 (2), 274-287
Ebigbo, A, and Gregory, S P. 2021. The relevance of microbial processes in geo-energy applications. Advances in Geo-Energy Research, Vol. 5 (1), 5-7
Morgan, H, Large, D J, Bateman, K, Hanstock, D, and Gregory, S P. 2021. Potential impacts of oxygen impurities in carbon capture and storage on microbial community composition and activity. International Journal of Greenhouse Gas Control, Vol.111, 103479
Barnett, M J, Palumbo-Roe, B, Deady, E A, and Gregory, S P. 2020. Comparison of three approaches for bioleaching of rare earth elements from bauxite, Minerals, Vol. 10 (8), 649.
Gregory, S P, Barnett, M J, Field, L P, and Milodowski, A E. 2019. Subsurface microbial hydrogen cycling: natural occurrence and implications for industry. Microorganisms, Vol. 7 (2), 53.
Barnett, M J, Palumbo-Roe, B, and Gregory, S P. 2018. Comparison of heterotrophic bioleaching and ammonium sulphate ion exchange leaching of rare earth elements from a Madagascan ion-adsorption clay. Minerals, Vol. 8 (6), 236
Barnett, M J,Palumbo-Roe, B, and Gregory, S P. 2018. Comparison of Heterotrophic Bioleaching and Ammonium Sulfate Ion Exchange Leaching of Rare Earth Elements from a Madagascan Ion-Adsorption. Clay Minerals, Vol. 8 (6), 236
West, J M, Jones, D G, Annunziatellis, A , Barlow, T S, Beaubien, S E, Bond, A, Breward, N, Coombs, P, de Angelis, D, Gardner, A, Gemeni, V, Graziani, S, Green, K A, Gregory, S P, Gwosdz, S, Hannis, S, Kirk, K, Koukouzas, N, Krüger, M, Libertini, S, Lister, T R, Lombardi, S, Metcalfe, R, Pearce, J M, Smith, K L, Steven, M D, Thatcher, K, and Ziogou, F. 2015. Comparison of the impacts of elevated CO2 soil gas concentrations on selected European terrestrial environments. International Journal of Greenhouse Gas Control, Vol. 40, 357–371
Watanabe, Y, Tait, K, Gregory, S, Hayashi, M, Shimamoto, A, Taylor, P, Stahl, H, Green, K, Yoshinaga, I, Suwa,Y, and Kita, J. 2014. “Response of the ammonia oxidation activity of microorganisms in surface sediment to a controlled sub-seabed release of CO2.” International Journal of Greenhouse Gas Control, Vol. 38, 171–181
Gregory, S P, Maurice, L D, West, J M, and Gooddy, D C. 2014. Microbial communities in UK aquifers: current understanding and future research needs. Quarterly Journal of Engineering Geology and Hydrogeology, Vol. 47 (2), 145–157. DOI: https://doi.org/10.1144/qjegh2013-059
Gregory, S P, Dyson P J, Fletcher D, Gatland P, and Shields R J. 2012. Nitrogen removal and changes to microbial communities in model flood/drain and submerged biofilters treating aquaculture wastewater. Aquacultural Engineering, Vol. 50, 37–45
Gregory, S P, Shields, R J, Fletcher, D, Gatland, P, and Dyson, P J. 2010. Bacterial community responses to increasing ammonia concentrations in a recirculating vertical flow saline biofilters. Ecological Engineering, Vol. 36, 1485–1491